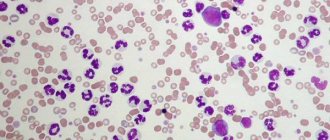

Дирофиляриоз – единственный гельминтоз умеренной климатической зоны, который передаётся трансмиссивным способом через укусы комаров. Заболевание регистрируют у теплокровных животных и человека. В этой статье расскажу, как развивается дирофиляриоз у собак, опишу лечение, методы диагностики, препараты для профилактики на основе последних наработок паразитологов и инфекционистов.
- Лабораторная диагностика дирофиляриоза у собак.
- Средство для уничтожения взрослых дирофилярий.
- Капли.
Что такое дирофиляриоз у собак
Заболевание вызывают круглые нитевидные черви рода Dirofilaria. Название переводится с латыни как «злая нить». Гельминты достигают в длину 15 – 30 см, в диаметре 1,3 мм.
В зоне умеренного климата регистрируют 2 вида дирофилярий:
- Dirofilaria immitis. Взрослые черви селятся с правой стороны сердца – в желудочке, предсердии, просвете лёгочной артерии.
- Dirofilaria repens. Половозрелые гельминты обитают под кожей – в клетчатке или мышцах.
При сильной инвазии черви иногда мигрируют в брюшную полость, головной, спинной мозг, селятся под веками и даже в глазном яблоке.
Собаки очень восприимчивы к дирофиляриям, легко заражаются и становятся основными носителями гельминтов. В одном животном могут одновременно паразитировать от 1 до 250 половозрелых червей. Промежуточные хозяева – комары рода Anopheles, Aedes, Culex. Насекомые переносят личинки от больных животных здоровым собакам и человеку.
Кошки, дикие представители псовых менее восприимчивы к дирофиляриям. У них реже встречается самая опасная сердечно-лёгочная форма болезни.
Жизненный цикл дирофилярии
Цикл развития гельминтов начинается в организме заражённой собаки. Живородящие самки взрослых дирофилярий ежедневно продуцируют личинки 1 стадии – микрофилярии. Они циркулируют в кровотоке заражённого животного до встречи с комаром, живут 2 – 3 года.
Видео с канала паразитолога Сергея Коняева. Микрофилярия Dirofilaria repens в крови собаки.
В момент укуса насекомое заглатывает личинки вместе с кровью. Внутри комара паразиты созревают до 2 и 3 стадии. Постепенно мигрируют в головной отдел насекомого и становятся заразными для животных и человека.
Продолжительность созревания личинок в теле комара зависит от температуры и влажности окружающей среды. Средний срок – 14 дней. При 20 – 28℃ и выше время сокращается до недели, при 18℃ и ниже увеличивается до месяца.
Когда температура опускается до 14℃, развитие микрофилярий останавливается, при нагревании воздуха возобновляется.
Когда инфицированный комар кусает здоровую собаку, личинки 3 стадии внедряются в кожу, проникают в подкожно-жировую клетчатку, где остаются до 21 дня. Затем кардионематоды Dirofilaria immitis поступают в кровоток и спустя 3 – 4 месяца с момента заражения достигают сердца. Подкожные паразиты Dirofilaria repens остаются в пределах подкожно-жировой клетчатки.
В организме собаки личинки дважды линяют. На четвёртой стадии увеличиваются до 1,8 см, на пятой – до 12 – 16 см. Спустя 6 – 7 месяцев с начала заражения половозрелые самки начинают продуцировать в кровь микрофилярии. Взрослые дирофилярии живут 5 – 7 лет.
Опасен ли дирофиляриоз собак для человека
Человек – нетипичный носитель дирофилярий. В России каждый год регистрируют 30 – 40 случаев заражения. Гельминты селятся под кожей, часто локализуются в области век и глаз. До половозрелой стадии не созревают. За всю историю зафиксировано всего 4 случая, когда черви добирались до сердца.
Личинки становятся инвазивными для человека на 3 стадии, когда развиваются в теле комара. Поэтому единственный способ передачи – трансмиссивный, через укус насекомого. Непосредственно от своей собаки владелец заразиться не может. Но животные влияют на частоту заболеваний в регионе: чем больше больных дирофиляриозом собак, тем выше риск заражения человека.
Что вызывает болезнь у собак, обусловленную сердечными глистами?
Болезнь, вызываемая сердечными гельминтами или дирофиляриоз является серьезным и потенциально смертельным заболеванием собак и других видов животных. Дирофиляриоз собак вызывается паразитом, известным как Dirofilaria immitis.
Взрослые сердечные черви обнаруживаются в сердце и прилегающих крупных кровеносных сосудах зараженных собак. Редко, паразиты могут быть найдены в других частях системы кровообращения. Самка данного глиста имеет длину 15 — 36 см и ширину (около 0,5-1 мм). Самец примерно в два раза меньше, чем у сама. При проведении патологоанатомической диагностики у одной собаки может быть найдено до 300 червей.
Дирофиляриоз в России – статистика
Заболеваемость дирофилярозом зависит от количества дней в году со среднесуточной температурой выше 14℃. На скриншоте приводится фрагмент методических указаний по дирофиляриозу Федеральной службы санитарно-эпидемиологического надзора РФ (2018 год):
Традиционно очаги дирофиляриоза регистрируют на юге России:
- в Краснодарском, Ставропольском крае;
- Крыму;
- Ростовской, Астраханской, Волгоградской области;
- республике Адыгея.
В 2021 – 2021 году исследование провели сотрудники новосибирского института систематики и экологии животных и московской ветеринарной лаборатории Vet Union под руководством известного паразитолога Сергея Коняева.
В основе исследований – анализ сотен публикаций с 1910 до 2019 года и результаты опроса практикующих ветеринаров. Для сбора информации на сайте www parasitology ru и в социальных сетях опубликовали анкету, которую заполнили 1039 врачей:
- 71,6% ветеринаров сталкивались с сердечно-лёгочной формой дирофиляриоза;
- 36,4% оценивают его как частое заболевание – 10 и больше случаев в год;
- 10,8% лечили только подкожную форму;
- 5,3% диагностировали сердечно-лёгочный дирофиляриоз хотя бы один раз.
За последнее десятилетие ареал расширился, болезнь регистрируют в следующих областях:
- Владимирская;
- Нижегородская;
- Ивановская;
- Тульская;
- Липецкая;
- Тюменская;
- Белгородская;
- Тамбовская;
- Курганская;
- Тульская;
- Свердловская;
- Еврейская автономная область;
- Кабардино-Балкария;
- Татарстан.
Полные результаты исследований опубликованы на странице Вконтакте.
Симптомы заражения
У дирофиляриоза нет ярких клинических признаков, которые чётко сигнализируют о заражении и помогают сразу поставить диагноз. Самые частые симптомы – повышенная утомляемость, потеря массы тела, слабость – сопровождают массу заболеваний.
На прогулках, тренировках пёс неохотно двигается, останавливается, присаживается, ложится. После физической нагрузки тяжело дышит, медленнее восстанавливается.
Если гельминты селятся в сердце, легочных артериях возникают симптомы дыхательной, сердечной недостаточности:
- Нарушение наполнения капилляров. При нажатии на десну нормальный розовый цвет возвращается дольше 2 секунд.
- Бледность или синюшность слизистых оболочек.
- Покашливание.
- Пенистая или кровянистая мокрота.
- Одышка.
- Шумное дыхание.
- Учащённое сердцебиение.
На осмотре ветеринарный врач замечает патологические изменения работы сердца: аномальные шумы, нарушение ритма, тахикардию.
Dirofilaria repens под кожей у собаки
Подкожные дирофилярии не затрагивают внутренние органы, но доставляют беспокойство животному. В местах локализации паразитов возникает:
- уплотнения;
- подвижные бугорки;
- высыпания;
- язвочки;
- зуд.
Из-за расчёсов выпадает шерсть, появляются ранки. Если в них попадают бактерии, развивается гнойное воспаление. Косвенно о заражении сигнализируют симптомы осложнений дирофиляриоза – увеличение печени, свободная жидкость в брюшной полости.
Дирофиляриоз — диагностика
Ставится диагноз с учётом следующих исследований:
- · рентгенологического. Обнаруживается, насколько расширена лёгочная артерия, а также показывается наличие гипертрофии правого желудочка;
- · лабораторного. Выявляет личинки путём изучения свежей капли крови — они хорошо видны между эритроцитами;
- · эхокардиографического. Наиболее используемая визуализирующая методика диагностики сердечно-сосудистых заболеваний.
Анализ на дирофиляриоз проводится комплексный. К перечисленным выше исследованиям добавляются еще одноразовые экспресс тесты, показывающие наличие антигена (потенциально опасного или чужеродного вещества). Эти экспресс системы обладают 100%-ой специфичностью.
ВАЖНО! Чем раньше хозяин животного обратится в ветлечебницу, тем точнее врач поставит диагноз и назначит правильное лечение.
Осложнения
Тяжёлые последствия возникают при сердечно-лёгочной форме:
- Тромбоэмболия лёгочных сосудов. После естественной гибели и в ходе лечения гельминты распадаются на фрагменты. Разлагающиеся паразиты частично или полностью закупоривают просветы сосудов и перекрывают ток крови к внутренним органам. Тромбоэмболия – главная причина гибели животного при дирофиляриозе.
- Эозинофильная пневмония. Возникает у собак с реакцией гиперчувствительности, как иммунный ответ на антигены циркулирующих в крови микрофилярий.
- Интерстициальная пневмония – воспаление стенок альвеол и соединительной ткани лёгких.
- Асцит – скопление свободной жидкости в животе.
- Гломерулонефрит – иммуновоспалительное поражение почечных клубочков. Осложнение возникает как реакция на бактерии-симбионты дирофилярий – вольбахии. Они сопровождают гельминтов, поддерживая жизнеспособность, репродуктивные функции.
- Гепатомегалия – увеличение печени из-за нарушения кровообращения.
- Респираторный дистресс-синдром – острая дыхательная недостаточность.
- Кардиогенный шок – крайняя степень сердечной недостаточности.
При подкожной форме на месте локализации червей иногда распространяется патогенная микрофлора и развивается абсцесс.
Причина возникновения дирофиляриоза сердца
Сердечный гельминт или дирофиляриоз является очень серьезным и потенциально смертельным заболеванием. Болезнь вызывается паразитом дирофилярией (Dirofilaria immitis).
Взрослые гельминты у зараженных собак находятся в сердце и в прилегающих к нему крупных кровеносных сосудах. Иногда червей можно обнаружить в других частях сердечно-сосудистой системы. Взрослая самка червя достигает 15-36 см в длину и 5 мм в ширину. Мужская особь составляет примерно половину размера самки. Одна собака во время диагностирования может иметь до 300 червей.
Взрослый сердечный гельминт может жить до пяти лет.
Взрослые гельминты могут жить до пяти лет и за это время самка производит миллионы потомков, называющихся микрофиляриями. Микрофилярии живут в основном в мелких сосудах.
Формы сердечно-лёгочного дирофиляриоза
Тяжесть состояния собаки определяют 3 фактора:
- Сроки носительства гельминтов: чем больше времени проходит с момента заражения, тем выше риск осложнений.
- Интенсивность инвазии: чем больше червей селятся в сердце, тем тяжелее протекает болезнь
- Индивидуальная резистентность животного.
По симптоматике сердечно-лёгочный дирофиляриоз протекает в трёх формах:
- Латентная. Заболевание развивается без клинических признаков. Пёс чувствует себя нормально, а хозяин даже не подозревает о болезни. Заражение выявляется случайно, когда в общем анализе крови обнаруживаются микрофилярии.
- Хроническая. Болезнь развивается медленно, с нарастающей симптоматикой. Сначала замечают 1 – 2 клинических признака, постепенно присоединяются другие.
- Тяжёлая. Эта форму диагностируют, когда в сердце скапливается целый клубок червей, а собака долго остаётся без лечения. У животного возникают признаки сердечной, дыхательной недостаточности.
На течение болезни влияет образ жизни собаки. При дирофиляриозе животному нужен полный покой. Если болезнь протекает скрыто, владелец не подозревает о заражении, не снижает физические нагрузки. На фоне бессимптомного течения у животного внезапно развиваются осложнения, состояние резко ухудшается.
Виды дирофиляриоза
Заболевание, в зависимости от вида паразита, протекает в кожной или сердечно-легочной форме. Тяжесть состояния собаки зависит от интенсивности инвазирования, а также от продолжительности патологического процесса. Сердечная форма представляет угрозу жизни собаки. Паразиты провоцируют опухолевидное разрастание ткани внутри кровеносного сосуда. Их заносит в головной или спинной мозг. Они колонизируют правый желудочек сердца и свиваются в клубки.
Наибольшую опасность представляют погибшие паразиты. Их обрывки способствуют формированию тромбов. Они забивают просвет сосудов и блокируют кровоток. При разложении червей образуются ядовитые метаболиты, развивается сильнейшая интоксикация. Нитчатые паразиты мешают работе сердца. Оно увеличивается в объеме, развивается кардиальная недостаточность.
Кожная форма дирофиляриоза жизни собаки не угрожает. Развиваются дерматиты, чаще всего на морде. Возникают потертости, облысения, припухлости.
Методы диагностики
При подозрении дирофиляриоза нужно выявить возбудителя, определить форму инвазии, проанализировать риск осложнений, исключить сопутствующие болезни. Поэтому потребуется комплекс исследований.
Лабораторная диагностика дирофиляриоза у собак
В ветеринарных клиниках гельминтов выявляют тремя способами:
- Метод нативного мазка. Капли свежей крови помещают между предметными стёклами и изучают под микроскопом. При заражении просматриваются подвижные полупрозрачные нитевидные микрофилярии. Это простой, доступный и одновременно неточный метод. При низкой степени инвазии личинки не попадают в пробы, и исследование показывает ложноотрицательный результат.
- Метод Кнотта. В пробирке смешивают кровь и 2% формалин, вращают в центрифуге. Затем сливают надосадочную жидкость, добавляют к осадку краситель, например, метиленовую синь. Этот метод точнее предыдущего. Микрофилярии окрашиваются и хорошо просматриваются под микроскопом. Метод Кнотта не определяет вид возбудителя. Если микрофилярий мало, они могут вообще не попасть в пробы.
Окрашенная микрофилярия крупным планом.
- Метод полимеразной цепной реакции (ПЦР). В венозную кровь добавляют ферменты, которые копируют фрагменты выделенного ДНК микрофилярий. Затем лаборант сверяет результаты с базой данных. Личинки легко обнаруживаются за счёт многократного увеличения ДНК возбудителя в пробах. Метод ПЦР диагностики – самый чувствительный и точный. Дирофиляриоз выявляется, даже если в крови циркулирует 1 микрофилярия, определяется вид личинок.
Если результаты отрицательные, но подозрения остаются, то исследования повторяют до 3 раз с недельными интервалами.
Экспресс тест
Для быстрого выявления дирофилярий проводят иммунохроматографический анализ. Он определяет в крови белок-антиген, который синтезируют взрослые самки сердечных дирофилярий.
Анализ проводят с помощью тест-кассеты. Кровь капают на отведённые зоны. Затем оценивают результат по количеству цветных полосок: 1 линия – положительно, 2 – отрицательно, нет полосок – ошибки.
Исследования занимают 5 – 15 минут, выявляют дирофиляриоз с высокой точностью только при интенсивном и долгом заражении. Ошибочные отрицательные результаты получаются в следующих ситуациях:
- с момента заражения прошло меньше 7 месяцев;
- в организме паразитируют только самцы;
- в сердце локализуются меньше 5 самок;
- собака получает профилактические препараты от гельминтов.
Если в лаборатории выявили микрофилярий методом Кнотта или нативного мазка, а тесты показывают отрицательный результат, то диагностируют подкожную форму дирофиляриоза.
Дополнительные исследования
При подтверждении заражения червями Dirofilaria immitis обследуют сердце, лёгочные артерии для оценки риска осложнений:
- Эхокардиография – выявляет патологические изменения работы сердца. Иногда во время исследования визуализируются взрослые дирофилярии.
- Электрокардиография – показывает частоту сердечных сокращений, нарушение ритма.
- Рентген грудной клетки – определяет увеличение правого предсердия, желудочка, аномальные изменения лёгочных артерий.
Для оценки общего состояния назначается клинический анализ крови.
Как диагностируется заболевание собак, обусловленное сердечными паразитами?
В большинстве случаев один или ряд простых анализов крови диагностируют наличие сердечных червей в организме собаки. Дальнейшие диагностические тесты необходимы для определения того, может ли собака безопасно пройти лечение данного заболевания. Перед началом лечения рекомендуются следующие диагностические процедуры: Серологическое исследование на наличие антигенов взрослых сердечных паразитов (тест на антиген, тест ELISA или SNAP): этот тест проводится на образце крови. Наиболее широко используемый тест обнаруживает антигены (белки), вырабатываемые взрослыми сердечными гельминтами. Он может быть положительным, даже если у собаки нет микрофилярий в кровотоке (примерно 20% случаев). Однако, следует помнить, что собаки с низкой степенью инвазии (менее чем четыре — пять взрослых паразитов) могут не продуцировать достаточный уровень циркулирующих антигенов для получения положительного результата теста, поэтому иногда могут возникать ложные отрицательные результаты у собак с низкой нагрузкой паразитов или на ранних стадиях инвазии. Поскольку обнаруженный антиген продуцируется только женскими особями дирофилярий, популяция только мужских особей также может дать ложный негативный результат.
Результат теста на микрофилярии (микроскопический тест капли крови или модифицированный тест Кнотта). Нативный образец крови, исследованный под микроскопом на присутствие микрофилярий. Для повышения точности диагностики образец крови центрифугируют и затем исследуют под микроскопом для обнаружения микрофилярий. Если микрофилярии видны, то тест считается положительным. Количество обнаруженных микрофилярий дает общее представление о степени тяжести инфекции. Тем не менее, микрофилярии будут обнаружены в кровотоке в большем количестве в летние месяцы и вечером, поэтому время отбора проб может повлиять на этот тест. Примерно 20% больных собак не показывают положительных результатов, хотя в их организме находятся сердечные черви, потому что их иммунная система приобрела способность разрушать микрофилярии. Кроме того, есть еще схожие паразиты крови, которые довольно часто встречается у собак, которые трудно отличить от микрофилярий. По этим причинам тест на антиген является предпочтительным для диагностики. Другие анализы крови (ОКА, биохимический анализ крови, электролиты) также необходимы для качественной диагностики.
Лечение дирофиляриоза у собак, препараты
Лечение сердечно-лёгочной формы включает 3 направления:
- Уничтожение взрослых гельминтов и личинок.
- Профилактика закупорки сосудов.
- Коррекция сердечный нарушений, профилактика и лечение осложнений.
Общей схемы не существует. Конкретные препараты назначает только лечащий ветеринарный врач после комплексной диагностики, оценки состояния животного и возможных рисков.
Препарат для уничтожения взрослых дирофилярий
Сейчас назначают единственное средство против половозрелых гельминтов – меларсомин, торговое название Иммитицид. Препарат разработали американские фармацевты в 1995 году. Он одобрен FDA, но в России не лицензирован и продаётся только в интернет аптеках.
До появления меларсомина для лечения дирофиляриоза пользовались средством тиацетарсамид. Препарат давал тяжёлые осложнения со стороны печени и почек, сейчас от него отказались.
Меларсомин – это токсичное соединение мышьяка. Он уничтожает половозрелых червей, не действует на личинок возрастом меньше 4 месяцев. Для собак в терапевтической дозе сравнительно безопасен.
По инструкции раствор вводят глубоко в поясничные мышцы 2 раза с интервалом 24 часа. Разовая доза меларсомина составляет 2,5 мг на 1 кг массы тела. В общей дозе 5 мг на 1 кг содержится 0,75 мг/1 кг мышьяка.
Практикующие ветеринары разработали свои схемы введения в зависимости от интенсивности заражения:
- 2 укола с интервалом 1 месяц.
- 1 инъекция, через 1 – 3 месяца ещё 2 с суточным интервалом.
При таких схемах гельминты погибают частями, снижается риск закупорки лёгочной артерии из-за быстрой массовой гибели паразитов. Меларсомин противопоказан животным с почечной, печёночной недостаточностью. Цена Иммитицида – 24 тысячи рублей.
После каждого укола полностью исключают физические нагрузки на 6-8 недель, ограничивают пространство для передвижения вплоть до содержания в клетке, выгуливают собаку на коротком поводке.
Препараты против микрофилярий
Личинки действуют не так разрушительно как взрослые черви, но тоже наносят вред. Нарушают микроциркуляцию крови, вызывают аллергическую реакцию у чувствительных животных. Для уничтожения микрофилярий применяют макроциклические лактоны, полученные из почвенного гриба:
- ивермектин
- мильбемицин;
- моксидектин;
- дормектин;
- аверсектин.
Взрослых особей они не уничтожают, но снижают жизнеспособность, подавляют репродуктивные функции.
Для уничтожения микрофилярий чаще назначают инъекционные растворы с ивермектином, аверсектином:
- Ивермек;
- Баймек;
- Новомек;
- Отодектин;
- Эпримек;
- Аверсект К&С.
Раствор вводят внутримышечно от 1 до 5 раз с интервалом 7 – 10 дней. Точную схему, дозу определяет лечащий врач по состоянию животного. После укола микрофилярии погибают в течение 4 – 24 часов.
Вспомогательная терапия
Поддерживающие препараты назначаются до введения меларсомина и после уничтожения гельминтов:
- Доксициклин – уменьшает популяцию бактерий вольбахий, которые осложняют течение инвазии.
- Алтеплаза – растворяет фибриновые сгустки в просвете сосудов. Они образуются из-за повреждений сердца и нарушения кровообращения. Алтеплаза вводится один раз внутривенным капельным путём.
- Преднизолон или Преднивет – подавляет активность иммунной системы в отношении антигенов возбудителя, сдерживает аллергическую реакцию.
- Гепарин – тормозит свёртывание крови, препятствует тромбообразованию.
- Курантил – улучшает венозный отток, микроциркуляцию крови в сердце, почках, стимулирует синтез интерферона.
Раньше при дирофиряозе назначали аспирин для разжижения крови и профилактики образования фибриновых сгустков. Теперь многие ветеринары от него отказались, считая пользу незначительной и недоказанной.
Хирургическое лечение сердечно-лёгочного дирофиляриоза у собак
Операцию назначают, если собаку приводят в клинику слишком поздно. Когда в сердце скапливается слишком много гельминтов, животное может не перенести медикаментозное лечение. Из-за массовой гибели червей после введения препарата возникает высокий риск полной закупорки сосудов сердца и лёгких.
На операции гельминтов удаляют из доступных для извлечения участков. Исход зависит от степени повреждений сердца, лёгких и артерий паразитами, оснащённости клиники и мастерства ветеринарных врачей. Если не удаётся извлечь всех червей, после операции назначается медикаментозное лечение.
Лечение подкожного дирофиляриоза у собак
Dirofilaria repens не угрожают жизни животного, поэтому сильнодействующий меларсомин не применяют. Чаще собаке прописывают средства для уничтожения микрофилярий. Препараты назначают в профилактических дозах курсом от 8 месяцев до нескольких лет – до естественной гибели червей. Иногда гельминтов извлекают через надрезы на коже.
Что происходит в организме собаки при дирофиляриозе?
Болезнь долгое время протекает скрыто. Данный период обычно занимает несколько лет, прежде чем у собаки проявляются клинические признаки инвазии. Следовательно, болезнь диагностируется в основном у собак от двух до восьми лет. Болезнь редко встречается у собак менее одного года, потому что время развития из микрофилярии макрофилярии занимают от пяти до семи месяцев после заражения. К сожалению, к тому времени, когда видны клинические признаки, заболевание имеет очень серьезную стадию.
Взрослые сердечные черви: Взрослые гельминты вызывают заболевание, закупоривая сердце и крупные кровеносные сосуды, ведущие от сердца. Они также мешают нормальной работе клапанов в сердце. Забивая магистральный кровеносный сосуд, снижается кровоснабжение других органов тела, особенно ухудшается приток крови к легким, печени и почкам, что приводит к нарушениям в работе этих органов.
Признаки дирофиляриоза зависят от количества взрослых червей, месторасположения червей, продолжительности жизни гельминтов у собаки и степени повреждения, которое получило сердце, легкие, печень и почки.
«Признаки болезни сердечного червя — это мягкий сухой кашель, одышка … и потеря выносливости». Наиболее очевидными клиническими признаками дирофиляриоза у собак являются мягкий сухой кашель, одышка, слабость, возбуждение, вялость и потеря выносливости. Все эти признаки наиболее заметны после физических нагрузок. Иногда некоторые собаки могут даже ослабевать или дезориентироваться. Ваш ветеринарный врач может заметить аномальные звуки в легких и сердце при аускультации с помощью стетоскопа. Нередко развивается застойная сердечная недостаточность с отеками в области конечностей и увеличением объема живота живот. В ряде случаев может развиться потеря веса, плохое общее состояние и анемии. Серьезно инфицированные собаки могут внезапно умереть во время физических упражнений или волнения.
Микрофилярии (незрелые сердечные черви) циркулируют в основном в небольших кровеносных сосудах. Поскольку они примерно такие же широкие, как капилляры, они могут блокировать кровоток в этих сосудах. Клетки, которые снабжаются этими капиллярами, не получают питательные вещества и кислород. Микрофилярии в первую очередь поражают легкие и печень. Поражение легочной ткани приводит к кашлю. Повреждение печени может привести к циррозу печени, вызывая синдром желтухи, анемию и генерализованную слабость. Почки могут также быть вовлечены в патологический процесс.
Препараты для профилактики дирофиляриоза
Для защиты от личинок дирофилярий пользуются антигельминтными каплями, таблетками или растворами. Репеллентные препараты не всегда спасают от комаров, их применяют как дополнительное средство.
В напряжённых по дирофияриозу регионах профилактику начинают в марте-апреле, за 1 месяц до начала сезона комаров. Заканчивают в октябре-ноябре, спустя месяц после окончания активности насекомых.
Капли
Самый простой способ защитить собаку от заражения – обрабатывать каплями на холку. Для профилактики дирофиляриоза одобрили препараты:
- Адвокат. Капли содержат комбинацию моксидектина и имидаклоприда. Первый компонент поступает в кровоток и выводится в течение 30 суток, второй распределяется в эпидермисе. Адвокат уничтожает личинки дирофилярий на 3 и 4 стадии, когда они внедряются в кожу и подкожную клетчатку после укуса инвазивного комара. Животное обрабатывают 1 раз в месяц.
- Стронгхолд. Капли содержат селемектин, выпускаются с концентрацией 6% – для щенков, 12% – для взрослых собак. Собаки благополучно переносят Стронгхолд, его назначают даже заражённым животным для снижения концентрации циркулирующих в кровотоке микрофилярий. Капли наносят каждые 30 дней. Собаку придётся обрабатывать дополнительно от иксодовых клещей, Стронгхолд с ними не справляется. В ветеринарных аптеках встречаются похожие капли с селемектином – Селафорт.
- ИН-АП комплекс. В состав препарата входит аверсектин С1, активный в отношении личинок дирофилярий. Интервал между обработками больше, чем у предыдущих капель – 6 недель. ИН-АП комплекс содержит ещё 2 противопаразитарных компонента: от клещей, блох, ленточных и круглых червей.
Если в доме живут подвальные комары, то собаку обрабатывают круглый год.
Таблетки
Для профилактики дирофиляриоза таблетки дают 1 раз в месяц.
- Нексгард Спектра. Препарат состоит из 2 активных компонентов: афоксоланера и мильбемицина. Первый защищает от наружных паразитов, второй – от нематод, в том числе от личинок дирофилярий. Таблетки выпускаются с разной дозировкой для 5 весовых категорий животных. Препарат противопоказан щенкам до 8 недель и взрослым собакам легче 2 кг. Цены Нексгард смотрите здесь.
- Мильбемакс. В таблетках содержится комбинация празиквантела и мильбемицина. Выпускаются 2 вида: для щенков и маленьких собак до весом 5 кг и для средних, крупных пород. Профилактическая доза мильбемицина для защиты от дирофилярий – 0,5 мг/кг. Мильбемакс разрешается давать щенкам с 2 недель.
- Гельмимакс. Таблетки содержат комбинацию празквантела и моксидектина. В аптеках продаются 3 вида таблеток: Гельмимакс 4, 10 и 20. Они предназначены соответственно для мелких, средних и крупных пород. Щенкам Гельмимакс разрешается давать с 3 недель.
- Диронет. Препарат состоит из 3 компонентов: ивермектин, пирантел и празиквантел. Щенкам разрешается с 3 недель. Для беременных собак противопоказан. Таблетки тоже выпускаются в 3 вариантах для маленьких, средних больших собак. Диронет содержит профилактическую дозу ивермектина: 0,006 мг/1 кг.
Растворы
Для профилактики пользуются препаратами с ивермектином, как и для лечения, но в микроскопических дозах. Растворы вводят внутримышечно или выпаивают 1 раз месяц.
Большинство препаратов сложно дозировать. Профилактическая доза ивермектина – всего 6 мкг, а в 1 мл раствора чаще содержится 10 мг. Проще рассчитать и набрать в шприц Отодектин. В нём на 1 мл жидкости приходится 1 мг ивермектина.
Лечение
У собак лечение заболевания кожного типа проводится медикаментозно и хирургически. Оперативное вмешательство требуется для извлечения взрослой особи дирофилярии. Местно поврежденные участки обрабатываются специальным раствором для нанесения на кожные покровы: Имидаклоприд 10% и Моксидектин 2,5%.
После одноразового применения раствора в крови у собаки не отмечалось наличия микрофилярий в течение 60 суток. Следов кожного поражения тоже не оставалось. Лечение собак с легочно-сердечной формой заболевания намного сложнее. При этом виде болезни можно уничтожить микрофилярий, применяя такие препараты, как Левамизол или Ивермектин.
Обычно этого достаточно для уничтожения личиночной стадии. Иногда такие средства используются в ситуации, когда лечение дирофиляриоза у собак с наличием половозрелых глистов представляет угрозу здоровью ослабленного пса. Если сразу убить взрослых паразитов, их останки приведут к резкому ухудшению самочувствия.
При наличии других патологий собака может сильно пострадать или даже последствия окажутся необратимыми.
Подбирать и назначать препараты от сердечных глистов у собак может только опытный и знающий ветеринар. Все это связано с тем, что для их уничтожения используются токсичные соединения мышьяка — меларсомина дигидрохлорид. Он может находиться в продаже под названием Иммитицид.
Это средство эффективно уничтожает взрослые особи гельминтов, но не может применяться, если у пса есть проблемы с почками, печенью, сердцем и легкими. К тому же у этого препарата есть еще один недостаток — он стоит очень дорого. В такой сложной ситуации собаку долго лечат при помощи Ивермектина.
Только лишь уничтожения паразитов недостаточно, это всего лишь первый этап терапии. После гельминтоза животные сильно ослаблены, их нужно восстанавливать и лечить поврежденные органы и системы организма. Для каждого конкретного пса составляется своя схема лечения в зависимости от тяжести и локализации поражений. Владельцам нужно быть готовым к тому, что лечение окажется очень длительным и сложным.
К сожалению, в некоторых особенно тяжких и запущенных случаях помочь животному не удается, и оно погибает. Наибольший вред наносят нематоды, провоцирующие поражения сердца и легких, с кожными паразитами удается справиться намного быстрее и эффективнее, и с меньшим ущербом для здоровья собаки.
Прогноз
Успех лечения определяют 4 фактора:
- количество половозрелых гельминтов;
- степень поражения сердца, артерий, лёгких;
- срок с момента заражения;
- ограничение подвижности животного.
Самый благоприятный исход при ранней диагностике, когда на момент выявления болезнь протекает бессимптомно или с 1 – 2 клиническими признаками. В этом случае дирофиляриоз бесследно проходит без осложнений. При запоздалом лечении и тяжёлой инвазии у собаки развиваются необратимые изменения легких и сердца, которые сокращают продолжительность жизни.
В статье использовались материалы с вебинаров доктора ветеринарных наук А.Н. Шинкаренко, статьи и рекомендации на форумах для владельцев собак паразитолога С. Коняева.